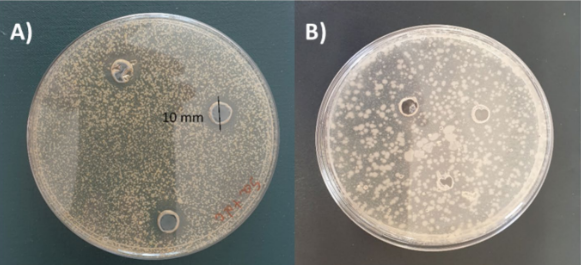

Did you know that beneath the skin surface lives a thriving ecosystem of microbes that work together to protect you? When this delicate balance is disturbed, a condition called skin dysbiosis makes your skin dry, inflamed, or more prone to acne. Many people try to fix this with harsh cleansers or antibacterial creams, but these often kill both harmful and helpful bacteria. What if, instead of wiping everything out, we could restore the skinās balance by adding back the āhelpfulā bacteria? Researchers recently found out that Lactobacillus casei, the same bacteria found in yogurt, helps rebalance the skinās microbial ecosystem. One of the main challenges in probiotic skincare is keeping live bacteria stable in a cream. The researchers solved the challenge by enclosing L. casei in alginateātapioca microspheres, which are tiny gel capsules that protect the cells from damage. These capsules were also coated with hyaluronic acid, an ingredient that keeps skin hydrated and helps preserve the probiotic until itās applied (ÅÄtocha et al., 2025)

Fig. 1. Flowchart of the encapsulation process (ÅÄtocha et al., 2025)
Can it fight harmful microbes?
To test whether the probiotic could defend against harmful bacteria, the researchers used two common microbiology methods, which are the time-kill assay and the well-diffusion assay. The time-kill assay measures how bacterial populations change over time, while the well-diffusion test finds clear zones around a sample that indicate antibacterial activity (ÅÄtocha et al., 2025).
Fig. 2. Well-diffusion assay showing antibacterial activity of Lactobacillus casei.
Inhibition zones observed in (A) Staphylococcus aureus; no inhibition in (B)
Staphylococcus epidermidis (ÅÄtocha et al., 2025)
As illustrated in Fig. 2, L. casei successfully inhibited the growth of S. aureus, which is a common skin pathogen, while leaving S. epidermidis, which is a beneficial skin bacterium, unaffected. The clear circle seen around the S. aureus colonies shows that L. casei released antimicrobial substances that are capable of slowing or preventing the pathogenās growth (ÅÄtocha et al., 2025).
Is the cream formulation safe for our skin?
The next step was to make sure the cream was safe for human skin cells. This was
tested using the 3-(4,5-dimethylthiazol-2-yl)-2,5-diphenyltetrazolium bromide (MTT) assay, a standard cell viability test that measures the metabolic activity of living cells (ÅÄtocha et al., 2025).

Fig. 3. Cell viability test (MTT) in (A) base formulation and (B) containing probiotic
microspheres. (ÅÄtocha et al., 2025).
As shown in Fig. 3, both the base and probiotic versions maintained over 75% viability when applied to cultured human keratinocytes and fibroblasts, indicating that the formulation was non-toxic (ÅÄtocha et al., 2025).
Can the cream be used to heal wounds on our skin?
Moreover, to see if the cream might help with wound healing, the researchers performed a scratch assay, which involves creating a small āwoundā in a layer of cells and observing how quickly the gap closes.

Fig. 4. Scratch assay for wound-healing evaluation. (A) Percentage of open wound area after 15 h for control, base (E1), and probiotic (E2) formulations. (BāG) Microscopic images showing closure at 0 h and 15 h for each treatment (ÅÄtocha et al., 2025).
As visualized in Fig. 4, the probiotic cream helped skin cells close the wound area faster than the base formulation or control. Within about 15 hours, the scratch was nearly fully healed in the probiotic group. To further explore this effect, the researchers used an enzyme-linked immunosorbent assay (ELISA) to measure two signaling molecules, IL-6 and IL-8, which are involved in cell repair and inflammation. These levels were slightly higher in the probiotic group, suggesting enhanced healing activity without triggering any irritation (ÅÄtocha et al., 2025).
The team also examined how the probiotic cream influenced the broader skin microbiome using colony-forming-unit (CFU) counts. The results from the researchers showed that the cream reduced harmful microbes such as Staphylococcus aureus, Escherichia coli, and Cryptococcus neoformans, while leaving beneficial bacteria unchanged (ÅÄtocha et al., 2025). Overall, the probiotic formulation promoted healing, maintained microbial balance, and remained gentle on skin cells (ÅÄtocha et al., 2025).
A New Kind of Skincare
Moreover, the results show that this probiotic cream doesnāt just sit on the surface, but it actively works with your skinās microbiome. The cream protects, heals, and restores balance instead of sterilizing it.
However, there are some important limitations to consider. The scratch assay used in the study only tested one type of skin cell, while real skin involves many cell types that interact in more complex ways. Since all of the testing was done in vitro, further research using full skin models or clinical trials will be needed to see how the probiotics behave on living skin, how long they stay active, and whether they remain safe with repeated use. (ÅÄtocha et al., 2025)
So, next time you are looking for a moisturizer, imagine a cream that doesnāt just hydrate but also seeds your skin with friendly bacteria working to keep it healthy from the inside out.
Reference: ÅÄtocha A., Michalczyk A., Bielecka E., Kantyka T., Miastkowska M., & Sikora E. (2025). Skin microbiome-friendly topical formulations containing probiotic-loaded alginate microspheres: in vitro studies. Scientific Reports, 15, 34246. https://doi.org/10.1038/s41598-025-16273-1
Cover photo: Yakult Mexico https://www.yakult.com.mx/2023/11/03/que-son-los-lactobacillus-casei-shirota/
No AI was used in the writing or editing of this material.